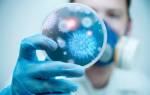

Формы выпуска
Антибиотик доступен в различных формах:
- капсулы (по 250-500 мг);
- таблетки (по 250-500 мг);
- порошок для приготовления суспензии (в 5 мл готового раствора содержится 125 или 250 мг активного компонента, в зависимости от формы выпуска).
Для лечения детей чаще всего используется суспензия Амоксициллин, которую необходимо разводить перед применением.
Врачи подчеркивают важность правильного применения амоксициллина у детей. Этот антибиотик часто назначается для лечения бактериальных инфекций, однако его использование должно быть строго контролируемым. Специалисты рекомендуют начинать с точной дозировки, основанной на весе ребенка и характере заболевания. Важно следовать указаниям врача и не превышать рекомендованную дозу, чтобы избежать побочных эффектов.
Кроме того, медики акцентируют внимание на необходимости завершения курса лечения, даже если симптомы исчезли раньше. Это поможет предотвратить развитие устойчивости бактерий к препарату. Родителям также советуют внимательно следить за состоянием ребенка во время приема амоксициллина и сообщать врачу о любых негативных реакциях. Правильное использование антибиотиков — залог успешного выздоровления и здоровья ребенка в будущем.

Принцип действия
Амоксициллин у детей быстро усваивается в желудочно-кишечном тракте. Максимальная концентрация в крови достигается всего через несколько часов. При этом прием пищи не влияет на его всасывание, а препарат устойчив к разрушению в желудке.
С кровотоком активное вещество быстро распространяется по организму. Оно проникает в ткани и биологические жидкости, обеспечивая необходимую концентрацию для борьбы с патогенными бактериями.
| Возраст ребенка (лет) | Дозировка Амоксициллина (мг/кг/сутки) | Частота приема |
|---|---|---|
| 3 месяца — 2 года | 20-40 | 2 раза в день |
| 2-5 лет | 20-40 | 2 раза в день |
| 5-10 лет | 20-40 | 2 раза в день |
| 10-12 лет | 20-40 | 2 раза в день |
| >12 лет | 25-50 | 2 раза в день |
При каких заболеваниях показан препарат
Можно назначить Амоксициллин ребенку при следующих заболеваниях:
- заболевания дыхательной системы;
- менингит;
- сепсис;
- патологии желудочно-кишечного тракта;
- отит и тонзиллит;
- инфекции мочеполовой системы;
- язвенная болезнь желудка.
Амоксициллин рекомендуется детям при наличии различных патогенных микроорганизмов, таких как:
- сальмонеллы;
- протеи;
- стафилококки;
- стрептококки;
- условно патогенные кишечные палочки;
- возбудители менингита и другие.
Благодаря широкому спектру действия, Амоксициллин пользуется высокой популярностью.
Мнения о применении амоксициллина у детей варьируются. Многие родители отмечают его эффективность в лечении бактериальных инфекций, таких как отит и пневмония. Важно, что препарат часто хорошо переносится детьми и имеет относительно низкий риск побочных эффектов. Однако некоторые мамы и папы выражают опасения по поводу возможной аллергической реакции и устойчивости бактерий к антибиотикам. Врачи советуют строго следовать назначенной дозировке и не заниматься самолечением, так как неправильное применение может привести к осложнениям. Также стоит учитывать, что амоксициллин неэффективен против вирусных инфекций, что подчеркивает важность консультации с педиатром перед началом лечения.

Дыхательные пути
Амоксициллин в форме сиропа для детей обычно назначается при острых заболеваниях дыхательных путей, вызванных патогенными микроорганизмами, включая:
- ларингит;
- бронхит;
- пневмонию;
- фарингит.
При этих инфекционно-воспалительных недугах детям рекомендуются не только сироп Амоксициллина, но и драже с добавлением клавулановой кислоты. Эти комбинации более эффективны в борьбе с патогенной флорой, обладают большей устойчивостью к микробным ферментам и быстро улучшают состояние пациента.
Правильный подбор дозировки Амоксициллина для детей крайне важен. Неправильно рассчитанная доза может вызвать аллергические реакции, включая приступы удушья, ангионевротический отек и поражение слизистых оболочек верхних дыхательных путей.
Мочеполовая система
Амоксициллин эффективен при различных заболеваниях мочеполовой системы. У детей это могут быть гломерулонефрит, пиелонефрит, цистит и уретрит, а также системные болезни, затрагивающие соединительные и мягкие ткани, включая эпидермис. В таких случаях антибактериальный препарат часто применяется в сочетании с другими средствами, что зависит от характера сопутствующих поражений. Комбинированные препараты более эффективно борются с патогенной микрофлорой, разрушая клеточную стенку и уничтожая бактерии.

Желудочно-кишечный тракт
Врачи часто назначают это средство детям при микробных инфекциях желудочно-кишечного тракта. Препарат зарекомендовал себя как эффективное средство для лечения язвенной болезни. Суспензия Амоксициллин подходит и для более серьезных заболеваний, так как она менее раздражает слизистые оболочки внутренних органов у детей. Однако при назначении этого антибактериального препарата необходимо проявлять осторожность, так как он может спровоцировать обострение язвенной болезни желудка или оказать токсическое воздействие на желудочно-кишечный тракт.
Инструкция по применению
Прием Амоксициллина следует начинать только после консультации с врачом. Специалист определит необходимую дозу для детей и частоту приема. Дозировка зависит от возраста, веса ребенка и типа заболевания.
При тонзиллите может использоваться стандартная или индивидуально подобранная доза. Амоксициллин назначают новорожденным и недоношенным детям при отите и тонзиллите. Обычно курс лечения не превышает 12 дней.
Для лечения ангины и отита детям рекомендуется принимать Амоксициллин в форме суспензии. Этот вариант легко проглатывается, имеет приятный вкус и не повреждает слизистую оболочку. Доза 125 мг подходит для самых маленьких пациентов. Не следует давать детям таблетки, так как они могут не справиться с их проглатыванием.
Прием средства детям до двух лет
Амоксициллин можно назначать детям, достигшим двухлетнего возраста. Однако его не рекомендуется использовать для малышей младше одного года. Врач должен подобрать альтернативное средство с более мягким действием. Разведенная суспензия может вызвать нежелательные реакции из-за вспомогательных синтетических компонентов.
Для детей в этой возрастной группе обычно рекомендуемая дозировка составляет 20 мг на килограмм массы тела. Прием таблеток с дозировкой 125 или 250 мг и выше не рекомендуется, так как это затрудняет определение нужного количества активного вещества. Наилучшим вариантом для детей этого возраста является Амоксициллин в форме суспензии.
Прием препарата от двух до пяти лет
В этом возрасте стандартная доза амоксициллина при серьезных заболеваниях составляет 250 мг. Обычная доза — 125 мг. Для детей младше пяти лет, особенно для трехлетних, препарат назначается только в форме суспензии. Четырехлетним детям амоксициллин рекомендуется давать в виде сиропа.
Употребление средства детям от пяти до десяти лет
Согласно инструкции, детям в возрасте от 5 до 10 лет не рекомендуется принимать таблетки. Врачи рекомендуют давать Амоксициллин детям до 10 лет в форме сиропа с дозировкой 250-500 мг три раза в день. Дозировку можно установить более точно.
Самостоятельное назначение Амоксициллина строго запрещено. Это должен делать только лечащий врач после осмотра ребенка и оценки его симптомов. В противном случае можно причинить значительный вред здоровью малыша. Амоксициллин для детей следует принимать не менее 5 дней, а курс лечения обычно составляет около 10 дней.
Детям старше 10 лет
Согласно рекомендациям, детям старше 10 лет и с весом более 40 кг препарат назначается в дозировке, аналогичной взрослой. Обычно это 500 мг за один прием трижды в день. При осложненном или тяжелом течении заболевания разовая доза может быть увеличена до 1 г, но максимальная суточная доза не должна превышать 6 г.
Если вес ребенка менее 40 кг, дозировка подбирается индивидуально с учетом тяжести состояния, массы тела и проявлений болезни. В некоторых случаях препарат можно принимать дважды в день, разделив общую дозу на равные части с интервалом в 12 часов.
Несоблюдение рекомендованных дозировок и частоты приема может привести к накоплению активного вещества в организме. Это может вызвать аллергические реакции, повышенную нервную возбудимость и расстройства пищеварительной системы.
Противопоказания и сторонние реакции
Несмотря на высокую эффективность, данный препарат имеет ряд противопоказаний:
- повышенная чувствительность к компонентам;
- заболевания почек и печени;
- аллергические реакции;
- дисбактериоз кишечника;
- инфекционный мононуклеоз;
- лейкоз.
Амоксициллин не рекомендуется при обострении почечной недостаточности. Замедленный вывод веществ из организма может привести к токсическим повреждениям органов и ухудшению состояния ребенка. Назначение препарата должно осуществляться только лечащим врачом.
Препарат на основе пенициллина может вызвать серьезные аллергические реакции у детей с повышенной чувствительностью.
Согласно статистике и отзывам, у некоторых маленьких пациентов могут возникнуть побочные эффекты, такие как:
- дисбактериоз;
- тошнота;
- рвота;
- покраснение кожи;
- конъюнктивит;
- насморк;
- беспокойство;
- перевозбуждение;
- бессонница.
При появлении этих симптомов необходимо прекратить прием препарата.
Отзывы
Препарат получает в основном положительные отзывы. Он эффективно устраняет как симптомы, так и причину заболевания. Побочные эффекты возникают довольно редко, и его можно принимать независимо от еды.
Существуют случаи, когда Амоксициллин не дает ожидаемого результата. Это может произойти, если перед началом лечения не был проведен анализ на чувствительность.
При сочетании с клавулановой кислотой препарат демонстрирует повышенную эффективность и меньше побочных реакций. Поэтому комбинация этих средств пользуется значительным спросом.
Амоксициллин назначают при различных заболеваниях, вызванных патогенной флорой, включая инфекции дыхательных путей, ЛОР-органов, мочеполовой системы, бактериальные поражения кожи и желудочно-кишечного тракта. Он широко используется в педиатрии, так как хорошо переносится детьми и эффективно лечит множество заболеваний.
Родителям следует внимательно следить за состоянием здоровья своих детей и избегать самолечения, так как это может привести к осложнениям и переходу острого течения болезни в хроническую форму.
Статья проверена
Анна Мошовис — семейный врач.
Вопрос-ответ
Как правильно давать амоксициллин детям?
Детям в возрасте 5-10 лет назначают по 250 мг (5 мл суспензии) 3 раза в сутки, детям 2-5 лет — по 125 мг (2,5 мл суспензии) 3 раза в сутки, младше 2 лет — 20 мг/кг массы тела в сутки, разделенные на 3 приема.
Как рассчитать дозу амоксициллина для ребенка по весу?
При весе ребенка менее 20 кг суточное количество препарата равно 25 мг/кг в 3 приема, при тяжелом течении заболеваний — 50 мг/кг. При весе более 20 кг (но менее 40 кг) суточная доза составляет 40–80 мг/кг в 3 (при низких дозах) или 2 (при высоких дозах) приема.
Можно ли давать амоксициллин 2 раза в день?
Обычно назначают 250 мг — 500 мг 3 раза в сутки или 500 мг — 1000 мг 2 раза в сутки. При синусите, внебольничной пневмонии и других тяжелых инфекциях рекомендуется назначать 500 мг — 1000 мг 3 раза в сутки. Максимальная суточная доза — 6 г. Обычно назначают 250 мг 2 раза в сутки.
Как правильно пить амоксициллин до еды или после?
Прием амоксициллина в домашних условиях: таблетки пролонгированного действия следует принимать в течение 1 часа после еды. Амоксициллин в других лекарственных формах можно принимать вместе с пищей или отдельно. Если прием препарата вызывает расстройство желудка, его необходимо принимать вместе с пищей.
Советы
СОВЕТ №1
Перед началом приема амоксициллина обязательно проконсультируйтесь с педиатром. Врач оценит состояние ребенка, поставит диагноз и определит необходимость назначения антибиотика, а также подберет правильную дозировку.
СОВЕТ №2
Следите за дозировкой и режимом приема. Амоксициллин обычно принимается через равные промежутки времени, чтобы поддерживать постоянный уровень лекарства в крови. Используйте мерную ложку или шприц для точного измерения дозы.
СОВЕТ №3
Обратите внимание на возможные побочные эффекты. У детей могут возникать аллергические реакции, такие как сыпь или зуд. Если вы заметили что-то необычное, немедленно обратитесь к врачу.
СОВЕТ №4
Не прекращайте курс лечения раньше времени, даже если симптомы исчезли. Это может привести к рецидиву инфекции и развитию устойчивости бактерий к антибиотикам. Завершите курс, назначенный врачом.